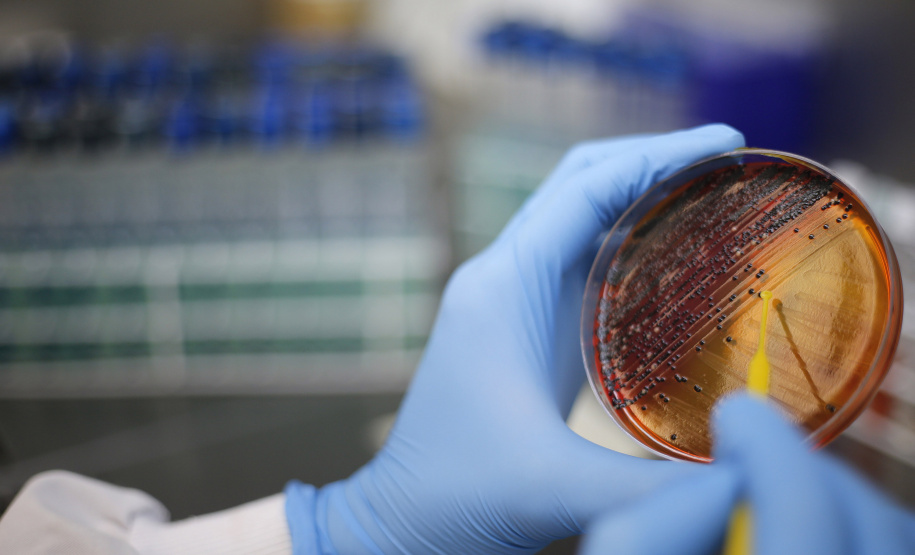
SETI

Pelo segundo ano consecutivo o Governo do Paraná anunciou um orçamento recorde para o financiamento de projetos e programas estratégicos da área de Ciência, Tecnologia e Ensino Superior. Previsto na Lei Orçamentária Anual (LOA) 2024, o aporte financeiro será de R$ 708,9 milhões – 37% maior que os R$ 517 milhões aplicados em 2023, maior número até então. O montante foi confirmado na 31ª reunião do Conselho Paranaense de Ciência e Tecnologia (CCT Paraná).
A dotação orçamentária é operacionalizada pelo Fundo Paraná, administrado pela Secretaria de Estado da Ciência, Tecnologia e Ensino Superior (Seti), instituição responsável pela gestão, distribuição e repasse dos recursos. Anualmente, o governo investe parte da receita tributária em iniciativas dessa área, conforme o artigo 205 da Constituição Estadual, o qual determina que os recursos sejam utilizados em projetos e programas que promovam o desenvolvimento do Estado de forma a melhorar a condição de vida dos paranaenses.
“Tivemos um salto em volume de recursos aplicados em programas e projetos de ciência e tecnologia a partir do ano passado. Saímos de R$ 100 milhões em 2022 para R$ 517 milhões em 2023. Para este ano houve a aprovação de R$ 708 milhões. Há, ainda, a possibilidade de suplementação orçamentária, o que dá efetivamente um bom aporte de recursos para que o Estado possa investir em programas e projetos de ciência e tecnologia, que ajudem a gerar desenvolvimento econômico e social”, destacou o secretário da Seti, Aldo Bona.
Os recursos do Fundo Paraná são distribuídos de acordo com o direcionamento do Conselho Paranaense de Ciência e Tecnologia, obedecendo os seguintes percentuais: 50% serão direcionados a projetos estratégicos da Seti, que em 2024 representam aproximadamente R$ 354 milhões. São projetos que têm promovido diferentes atividades nas universidades e centros de pesquisa do Paraná.
- Com pesquisa e iniciativas pioneiras, Paraná pode se tornar a terra do lúpulo no futuro
- Com salto da UEM e estreia da Unespar, universidades estão entre as melhores da América
Os recursos de fomento científico e tecnológico são destinados a manter projetos voltados ao desenvolvimento de pesquisa, como a implantação de um laboratório para a produção de insumos para diagnóstico veterinário, que está sendo construído pelo Tecpar; bolsas-auxílio para estudantes e profissionais; desenvolvimento e promoção de Novos Arranjos de Pesquisa e Inovação (Napis), que reúnem pesquisadores de diferentes áreas do conhecimento; fomento e desenvolvimento de iniciativas públicas e privadas para estimular o avanço para soluções de questões da sociedade.
A outra metade é dividida entre a Fundação Araucária, a Secretaria de Estado da Inovação, Modernização e Transformação Digital (25%), o Instituto de Tecnologia do Paraná (Tecpar), o Instituto de Desenvolvimento Rural do Paraná (IDR) e o Instituto Paranaense de Desenvolvimento Econômico e Social (Ipardes), que juntos recebem 25%.
O presidente do Grupo Viasoft, Itamir Viola, também conselheiro do CCT, afirma que o investimento representa um grande fomento da ciência. “Estamos vivendo um momento de amadurecimento do uso do recurso público. O Estado está comprometido a seguir a trilha completa, desde a pesquisa básica, passando pela pesquisa aplicada, com resultados medidos na ponta. Trata-se de um movimento de inovação muito grande com startups e empresas inovadoras que recebem essas tecnologias e geram produtos e serviços para melhorar a qualidade de vida”, destacou.
Nessa reunião do CCT Paraná, os representantes dos órgãos que recebem recursos do Fundo Paraná apresentaram os relatórios de prestação de contas de 2023 e também o plano de ação para 2024. No mesma encontro o CCT aprovou a Política Estadual de Ciência, Tecnologia e Inovação (Pecti), uma ação inédita do Governo do Estado. Com ações previstas até 2030, a próxima etapa para implementação da Pecti é a publicação de um decreto, oficializando a vigência das novas diretrizes para o desenvolvimento científico e tecnológico paranaense.